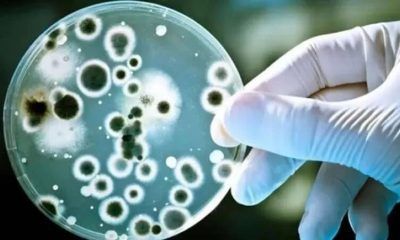
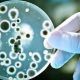

En enero, a cobrar en febrero, la suba es del 40%. Y en febrero, a pagarse en marzo, del 26%. Acumulada, supera el 75%. La Justicia...


La adopción de la quinta generación de banda ancha móvil permitirá impulsar de manera masiva el Internet de las cosas y descongestionar las redes 3G y...


El desarrollo investiga y apunta a las «señales» que el estómago manda al cerebro. En un avance sin precedentes en la lucha contra la obesidad, investigadores...


La devaluación encareció la importación y eso se traslada directo a los precios. Los jubilados, entre los más perjudicados. En medio de la fuerte suba...

En diálogo con la Barra de Casal el Dr. Matías Lahitte, a cargo del área de epidemiologia municipal destacó que se observa un aumento de las...


Las Sociedades de Cardiología de todo el país sacaron un duro comunicado donde advierten sobre la postergación de intervenciones y serias complicaciones con las urgencias. El...


En el Día Internacional de lucha contra el Cáncer de Mama, que se conmemora hoy 19 de octubre, es importante recordar las medidas de prevención y...
/cloudfront-us-east-1.images.arcpublishing.com/artear/3TFEEVBEX5AEFPAXCJCD7QDSPA.jpeg)
/cloudfront-us-east-1.images.arcpublishing.com/artear/3TFEEVBEX5AEFPAXCJCD7QDSPA.jpeg)
Es un procedimiento que consiste en administrar medicamentos o radiofrecuencia en nervios causantes de dolor. Riesgos y ventajas.
:quality(80)/cloudfront-us-east-1.images.arcpublishing.com/lanacionar/7Q54X2CODRCLJJ42GBT6OKQPK4.JPG)
:quality(80)/cloudfront-us-east-1.images.arcpublishing.com/lanacionar/7Q54X2CODRCLJJ42GBT6OKQPK4.JPG)
En Orán, el hospital está saturado de pobladores que llegan con los síntomas de dengue o chikungunya y relatan que en los barrios o las comunidades...


GASTON PAULS ESTUVO EN OLIVEROS ABORDANDO EL TEMA ADICCIONES ANTE CIENTOS DE JÓVENES Gaston Pauls, reconocido actor, director y productor de cine y televisión estuvo recientemente...